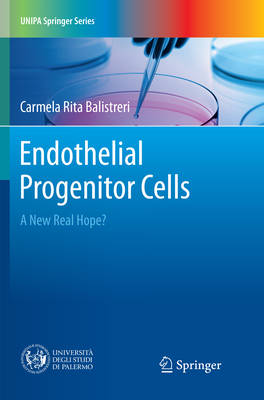

- Retrait en 2 heures
- Assortiment impressionnant
- Paiement sécurisé
- Toujours un magasin près de chez vous
- Retrait en 2 heures
- Assortiment impressionnant
- Paiement sécurisé
- Toujours un magasin près de chez vous
Description
This book explores the role of endothelial progenitor cells (EPCs) in the context of regenerative medicine (RegMed). In particular, it reveals the value of RegMed as a new TM branch intended to improve the health and quality of life, by restoring, maintaining or enhancing tissue and functions of organs.
The book is divided into three chapters, the first of which describes the relevance of translational medicine (TM) as a new research approach to counteract the imposing challengeof age-related diseases. Of the diverse RegMed approaches, particular attention is paid to stem/progenitor cell-based therapies, their benefits and shortcomings, as well as to the description of types of stem and progenitor cells considered for regenerative cell therapies, such as EPCs as emerging candidates for RegMed applications.
In turn, the second chapter outlines the clinical relevance of EPCs as both potential predictors, diagnostic and prognostic biomarkers of age-related diseases and therapeutic agents,discussing their advantages, disadvantages, and conflicting data.
Chapter three proposes a potential roadmap for revising the findings and creating a clearer picture of valid data, which can provide support for various important aspects, i.e.isolating and characterizing EPCs by establishing standardized criteria for EPC research, identifying appropriate sub-populations for cell therapy, timing, dosing, priming of cells,and defining delivery modes for different applications.
The book concludes with an overview of innovative strategies that could improve the efficacy of cell therapy at all levels, including cell priming, bio-nanotechnology, and tissue engineering.
Spécifications
Parties prenantes
- Auteur(s) :
- Editeur:
Contenu
- Nombre de pages :
- 80
- Langue:
- Anglais
- Collection :
Caractéristiques
- EAN:
- 9783319855691
- Date de parution :
- 02-08-18
- Format:
- Livre broché
- Dimensions :
- 155 mm x 5 mm
- Poids :
- 191 g

Seulement chez Librairie Club
Les avis
Nous publions uniquement les avis qui respectent les conditions requises. Consultez nos conditions pour les avis.